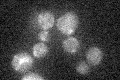
YDL104C
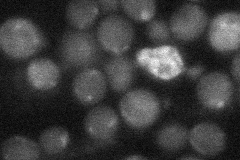
YDL104C

View description
Highly conserved mitochondrial protein, essential for stability of the mitochondrial genome; functional homolog of the essential E. coli ygjD gene; member of a family of proteins putatively involved in genome maintenance
Localization:
Intensity:
Fold change:
Significance:
-
C’ GFP library in SD
mitochondria18.25 -
N' NOP1pr-GFP in SD

mitochondria52.3821 -
N' TEF2pr-mCherry in SD

missing0 -
N' NATIVEpr-GFP in SD
below threshold26.035 -
N' TEF2pr-VC and Cyto-VN in SD

#N/A0 -
C’ GFP library in SD+DTT

mitochondria21.391.17No -
C’ GFP library in SD+H2O2

mitochondria19.111.04No -
C’ GFP library in Starvation Media

mitochondria19.951.09No -
C’ GFP library on the background of Pup2-DaMP

mitochondria -
C’ GFP library on the background of CCT mutant

mitochondria19.80351.08481No
